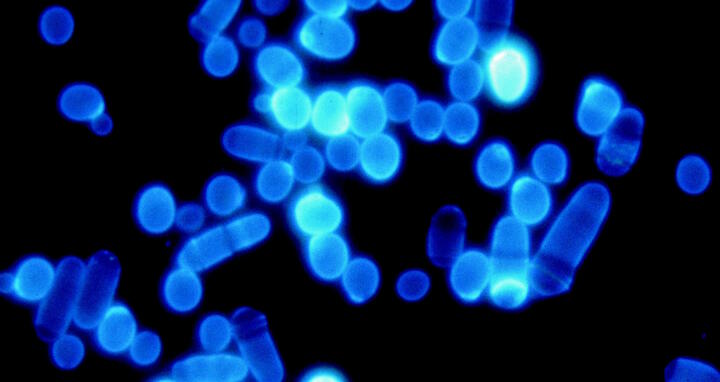

Protein quality control in the cell: Waste removal more efficient than expected
Proteins are in charge of almost everything in an organism: they provide building material for cells, transport oxygen through the blood, enable muscles to function, control metabolism and carry out many more functions. In short, they keep the body going. This variety of proteins is produced by small molecular machines called ribosomes, many of which sit on the surface of a cell organelle, the Endoplasmatic Reticulum. In this process cells often make mistakes in folding proteins into the form they need to function. Such misfolded molecules have to be eliminated, along with intact proteins that have fulfilled their purpose and are not needed anymore by the cell.
Waste removal is essential for the cell
“If these proteins are not disposed of properly, they can accumulate in the cells and cause severe damage,“ says Annika Weber, PhD student in the research group “Intracellular Proteolysis” led by Prof. Thomas Sommer at the MDC. She is first author of the recent study in Molecular Cell. A failure to eliminate defective proteins can trigger diseases like Alzheimer, Parkinson or Huntington. Thus, for the organism it is vital that these proteins are removed by the cellular waste disposal machinery and disassembled in the proteasome, the shredder of the cell.
Over the last few years, researchers have been able to discover many of the details by which this highly complex process of protein degradation occurs. However, many questions remain unanswered. They include the question of how proteins that have to be eliminated can be identified among the great diversity of cellular molecules and marked for waste removal.
A chain of ubiquitin molecules (orange, pink) serve as labels when attached to a protein (blue). Image: CC-BY‑4.0, David Goodsell/RCSB PDB.
Ligase enzymes mark proteins that need to be destroyed
Enzymes called ligases, including a molecule called Doa10, play a key role in protein quality control. Doa10 is embedded in the membrane enclosing the Endoplasmatic Reticulum and nucleus and is capable of identifying aberrant proteins. It binds to them, draws in additional enzymes, and forms a machine consisting of the components that transmit signals for degradation. The next step is crucial: a small molecule called ubiquitin is attached to the defective proteins. More ubiquitin molecules are added until a homogeneous chain is formed. This creates a label that marks the protein for destruction. Only then is it transported to the proteasome and broken down.
“We wanted to know more about how this ubiquitin chain is formed,“ Annika says. The scientists knew that an enzyme called Ubc7 is involved. “For a long time the dogma was that this one enzyme alone is capable of performing both tasks: Attaching the first ubiquitin to the protein and adding additional ubiquitin molecules to form a chain.”
Searching for clues in yeast cells
However, there was also evidence that Ubc6, a second enzyme, is involved. Annika and her colleagues decided to investigate its role in yeast cells. The system of protein degradation is so essential for organisms that the basic machinery has been preserved in a similar form in all living beings – from yeast cells to humans – through evolution.
The researchers genetically manipulated yeast cells so that they were unable to produce either Ubc6 or Ubc7, then examined the degradation rates of specific proteins. In another set of experiments, they isolated both enzymes from the cells and used biochemical methods to investigate whether this caused differences in the way ubiquitin molecules were attached to proteins. This part of the project required support from the MDC Technology Platform for Mass Spectrometry.
Various enzymes share the work
It turned out that Ubc6 also plays a key role in the labeling of molecules as waste. Ubc6 binds the first ubiquitin label to the faulty protein. Ubc7 then steps in to add more ubiquitin molecules. It was an important discovery: by sharing the work, two enzymes make the process more effective. While Ubc7 is specialized in the formation of the homogenous ubiquitin chain, Ubc6 can initiate the chain, attaching it to different proteins.
Another observation supported the finding: proteins are made from 20 different amino acids; until now it was assumed that ubiquitin can only be attached to a specific amino acid called lysine. The researchers from the MDC showed that Ubc6 can also attach the label to serine and other amino acids. “This makes the signaling pathway more robust,” Annika explains. “It is essential that the organism remove all defective proteins, even those that don’t have lysine exposed and accessible on their surfaces.”
The researchers were further able to show that humans have an enzyme that corresponds to yeast Ubc6, called UBE2J2, which apparently performs the same function. To find out, they isolated the enzyme from human cells und investigated its activity in the formation of the ubiquitin chains in vitro.
The next step for Thomas Sommer’s group will be to examine the properties of Ubc6 in more detail. The recent study has shown for the first time that the enzyme plays a decisive role in the efficient labeling of defective proteins. A clearer understanding of how Ubc6 manages this on a molecular level will contribute to a better understanding of the key cellular process of protein degradation, and the diseases that arise from defects in the process.
Annika Weber,1 Itamar Cohen,2 Oliver Popp,3 Gunnar Dittmar,3 Yuval Reiss,2 Thomas Sommer,1,4 Tommer Ravid,2 and Ernst Jarosch,1 ”Sequential Poly-ubiquitylation by Specialized Conjugating Enzymes Expands the Versatility of a Quality Control Ubiquitin Ligase.“ Molecular Cell 63. DOI: 10.1016/j.molcel.2016.07.020
1Intracellular Proteolysis, Max Delbrück Center for Molecular Medicine, Berlin, Germany; 2Department of Biological Chemistry, The Hebrew University of Jerusalem, Jerusalem, Israel; 3Mass Spectrometric Core Facility, Max Delbrück Center for Molecular Medicine, Berlin, Germany; 4Institute of Biology, Humboldt Universität zu Berlin, Berlin, Germany
First-authors Annika Weber and Itamar Cohen equally contributed to the publication.
Featured image: Fluoresceing yeast cells. In the experiment they serve as model organisms. Image: CC-BY 3.0, CSIRO.